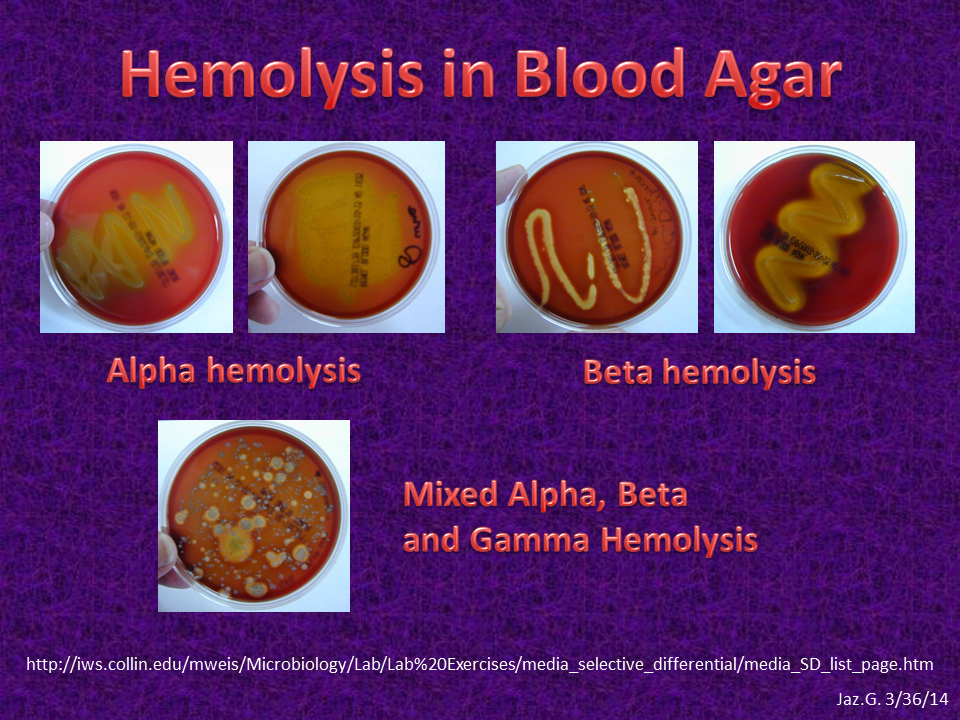

Hemolytic Patterns On Blood Agar is a flexible and inexpensive source for crafting, scrapbooking, and do it yourself tasks. With endless layout options, you can discover patterns that match every style and occasion, from flower and geometric prints to holiday-themed layouts. These papers are ideal for developing tailored cards, wrapping presents, or adding ornamental elements to your crafts.
Easy to download and install and publish, pattern paper saves time and money, making it a go-to service for hobbyists and professionals alike. Whether you're working on an institution task or embellishing your home, printable pattern paper supplies a creative and hassle-free means to bring your concepts to life.
Hemolytic Patterns On Blood Agar

Hemolytic Patterns On Blood Agar
Find Mickey Mouse Pattern stock images in HD and millions of other royalty free stock photos illustrations and vectors in the Shutterstock collection Browse 191 incredible Mickey Mouse Pattern vectors, icons, clipart graphics, and backgrounds for royalty-free download from the creative contributors at ...
Customizable Mickey Mouse templates Canva

Solved Blood Agar Questions 9 What Type Of Hemolysis Is Chegg
Hemolytic Patterns On Blood AgarFree Sewing Pattern for a Mickey Mouse inspired earbud pouch sewing pattern, a cute Disney DIY craft project to make before your vacation. Check out our mickey mouse seamless pattern selection for the very best in unique or custom handmade pieces from our drawings sketches shops
The free Mickey Mouse Felt Sewing Pattern is a fun and simple project that allows you to create your own adorable Mickey Mouse hand-shaped ... ALPHA AND BETA HEMOLYTIC STREPTOCOCCUS Laboratory Exercises In Blood Agar The Hemolysis Test Theory Results YouTube
Mickey Mouse Pattern Vector Art Icons and Graphics for Vecteezy

Blood Agar Alpha Beta Gamma
Find Download Free Graphic Resources for Mickey Mouse Pattern Vectors Stock Photos PSD files Free for commercial use High Quality Images PPT Practical No 10 Streptococcus Species PowerPoint Presentation
A Mickey Mouse template is a ready to use Mickey Mouse figure or outline which can be downloading and the outline can then be sketched The rest of the features Beta hemolysis Blood Agar Microbiology Old Fashion Pinterest Blood Agar Alpha Beta Gamma

Culture Media 1

Microbiology Hemolysis Blood Agar YouTube
Veterinary Ebooks And Lecture Notes FREE Hemolysis In Blood Agar

Gambar Koloni Pada Agar Darah 35 Koleksi Gambar

Blood Agar Composition Preparation Uses And Types Of Hemolysis

BLOOD AGAR Microbiology Laboratory Turkey
Measuring Hemolytic Activity Using Blood Agar Media Hemolytic Activity

PPT Practical No 10 Streptococcus Species PowerPoint Presentation

Gram Positive Bacilli Rods Microbiology Learning The why ology Of

Blood And Bacteria Blood Agar Reveals How Microbes Consume Blood